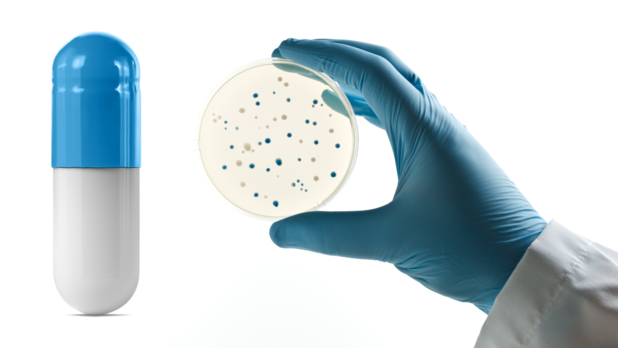

- 04 septembre 2024
- En Martine Versonne
- | Source: De Apotheker
La taxation des antibiotiques, arme contre la résistance microbienne
Comment lutter contre l'augmentation de la résistance aux antimicrobiens? En jouant sur le prix comme viennent de le démontrer des chercheurs britanniques qui suggèrent qu'une taxation ciblée est très efficace pour déplacer la demande vers les antibiotiques à spectre étroit.
Désolé, il s'agit d'un article premium.
Cet article est exclusivement disponible pour les abonnés de Dobbit. Abonnez-vous maintenant et accédez à tout les articles.
Découvrez nos formules d'abonnement